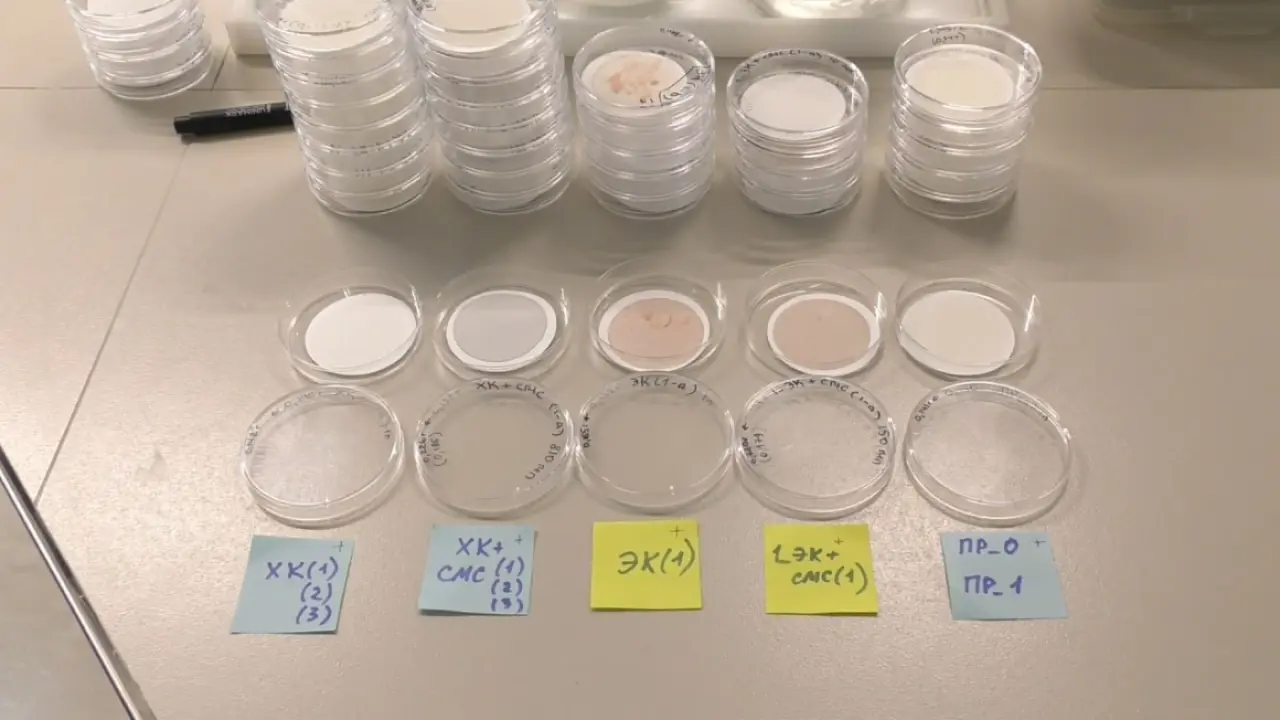

Пластик в деталях

Утренний кофе, рыба, комары и даже пчёлы — где ещё находят микропластик? В России одним из центров, где системно изучают этот вид загрязнителя, стал Центр исследования микропластика Томского государственного университета.
Руководитель центра, Юлия Франк, директор Центра исследования микропластика в окружающей среде ТГУ, стала первой в стране, кто защитил докторскую диссертацию на эту тему. Мы поговорили с ней о том, как микрочастицы полимеров перемещаются по средам, накапливаются в живых организмах и влияют на жизнь вокруг нас.

Что такое микропластик?
Юлия Франк:
«Микропластик — это любые твёрдые синтетические частицы, которые имеют размеры до 5 миллиметров. Это могут быть сферы, обломки, микроволокна — любой формы и различного состава. Крупный микропластик мы можем увидеть глазом, более мелкие частицы — только под микроскопом. Почему тема микропластика сейчас так актуальна? Потому что очень мало данных по поводу его источников, его транспорта, его судьбы в окружающей среде, а особенно относительно воздействия на живые организмы».
Где микропластик ищут томские учёные?
Микропластик перемещается между средами: водой, почвой, воздухом. В ТГУ за пять лет научились отслеживать его маршруты.
Юлия Франк:
«Наш центр существует уже пять лет. Мы работаем с самыми разными объектами живой и неживой природы, потому что понимаем циркуляцию микропластика как проблему мирового масштаба и рассматриваем частицы микропластика как объекты, которые перемещаются между средами. Они есть в атмосфере, почвах, поверхностных водах, живых организмах, осадках.
Есть пути транспорта, которые соединяют среды. Например, в водную среду микропластик попадает с городских территорий: со свалок, вместе со сточными водами. В атмосферу — из текстильных изделий, с дорожной разметкой, при стирании автомобильных шин.
В нашем центре проводились исследования по переносу микропластика комарами: личинки развиваются в воде, а взрослые особи вылетают на сушу и могут переносить частицы.
У нас есть работы, посвящённые количественному учёту микропластика в реках, в озёрах, в воде, в донных отложениях, в пробах снега, в живых организмах, в рыбах, моллюсках, иглокожих.
В этом году начинается исследование, которое будет посвящено количественной оценке микропластика в продуктах пчеловодства и в самих пчёлах. Потому что сейчас на многих пасеках используются пластиковые ульи и это может быть источником загрязнения мёда.
Мы также проводим модельные эксперименты: в условиях лаборатории моделируем загрязнение и смотрим, как живые организмы поглощают его и оказывает ли микропластик на них воздействие».

Как извлекают частицы из тканей рыб
В 2024 году центр получил патент на метод извлечения микропластика из тканей рыб.
Юлия Франк:
«Мы разработали метод для извлечения микропластика из органов и тканей рыб. Он основан на щелочном гидролизе тканей и последующей обработке раствора. Это позволяет получить чистый препарат, удалив всё ненужное. Работа с пробами биоматериала сложна, но этот метод даёт оптимальный результат».
Что будет, если съесть такую рыбу?
Юлия Франк:
«Ничего не будет, потому что мы все окружены микропластиком, как и другими загрязнителями окружающей среды. Вокруг нас витает огромное количество частиц и молекул, которые потенциально токсичны. Всё зависит от концентрации. Микропластик — не самый опасный загрязнитель из всех, что мы знаем. Есть, например, стойкие органические загрязнители или тяжёлые металлы, такие как кадмий, ртуть, свинец. Их токсичность доказана, а для микропластика острая токсичность пока не подтверждается».
После стирки…
Синтетические ткани, особенно флис, выделяют микроволокна при стирке и являются одним из главных источников загрязнения водоёмов микропластиком. Чтобы исследовать этот процесс, в лаборатории ТГУ организовали «научную прачечную».
Юлия Франк:
«Мы проводим серию экспериментов, в которых количественно оцениваем, сколько микроволокон попадает в сточные воды при стирке изделий из флиса. Флис — это синтетический материал, он делается из ПЭТ, одного из полиэфиров, из которого также делают пластиковые бутылки.
Мы стираем вещи с синтетическими моющими средствами и без них, проводим контрольные стирки. Нас интересует, в том числе, уменьшается ли количество оставшихся в воде микроволокон при повторных стирках.
Предмет одежды стирают 50 раз, воду из стиральной машины не сливают в канализацию, а фильтруют и исследуют.
Гораздо меньше микроволокон появляется в сточных водах без использования синтетических моющих средств. Синтетические моющие средства, особенно порошки, довольно абразивные и способствуют и стиранию тканей, и высвобождению вот этих волокон.
Также удалось установить, что с каждой повторной стиркой из флисовой толстовки выделяется в воду всё меньше микроволокон.
Это довод против быстрой моды: лучше носить одну одежду подольше, чем покупать постоянно новые вещи и их стирать».

Фильтр против микроволокон
Чтобы сократить попадание волокон в воду, в ТГУ разрабатывают фильтр для стиральных машин.
Юлия Франк:
«Мы разрабатываем фильтр, который может использоваться в домашних условиях. Он будет совместим с разными моделями стиральных машин. Люди, которые хотят повлиять на ситуацию с загрязнением окружающей среды, смогут устанавливать такой фильтр и задерживать максимальное количество микроволокон синтетического текстиля.
Гораздо проще улавливать их сразу на выходе из стиральной машины, чем потом устраивать дополнительные этапы на очистных сооружениях. Это будет эффективнее и дешевле».
Первый прототип фильтра учёные планируют получить уже в начале 2026 года.

Микропластик в реках
Специалисты ТГУ отобрали пробы воды из сибирских рек, чтобы оценить концентрацию микропластика в водной экосистеме.
Юлия Франк:
«Мы исследовали пробы воды и донных отложений из Оби и Енисея. Загрязнение там характеризуется преобладанием волокон по сравнению с фрагментами и плёнками.
Микросферы и микроволокна чаще всего попадают в водные экосистемы уже в микроразмерном виде с бытовыми сточными водами или из промышленных источников, а вот микрофрагменты являются вторичными по своему происхождению, то есть накапливаются в результате распада более крупных пластиковых изделий, и их присутствие может быть связано с замусориванием берегов.
Мы увидели, что количество микропластика существенно не увеличивается от верхнего течения к нижнему. Это значит, что реки не только транспортируют, но и поглощают эти частицы: они перераспределяются между водой, донными отложениями, поймой и живыми организмами».

Влияние микропластика на окружающую среду
Как микропластик влияет на живые организмы, опасен ли он для человека? Ответа пока нет — слишком мало данных и слишком много нюансов.
Юлия Франк:
«Вопрос о его влиянии остаётся открытым. Есть экспериментальные данные о негативном воздействии микропластика на физиологию разных групп живых существ. Но есть и исследования, которые не подтверждают этот эффект.
Микропластик — это не одна молекула, а огромное разнообразие частиц разного состава, формы и происхождения. Поэтому действовать они могут по-разному: и сами по себе, и как транспорт других токсичных веществ. Может происходить адсорбция токсичных загрязнителей из окружающей среды на поверхности частиц, то есть они выступают как носитель, например, для тяжёлых металлов, для стойких органических загрязнителей, которые вместе с пищей и водой могут употребляться живыми организмами.
Негативное влияние микропластика на организм человека на данный момент не доказано. Но исследований очень много, и этот вопрос активно изучается.
Мы все окружены микропластиком, как и другими загрязнителями окружающей среды. Вокруг нас витает огромное количество частиц, огромное количество молекул, которые потенциально токсичны. Всё зависит от концентрации, и микропластик — это не самый опасный из всех».

Что можно сделать?
Юлия Франк:
«Много страхов, но мало данных, поэтому интерес к теме так высок. Термин «микропластик» появился в 2004 году — всего 20 лет назад, это очень мало для науки. Сейчас идёт период накопления данных.
Все наши усилия направлены на то, чтобы создать систему мониторинга этого загрязнителя и технологии, препятствующие его поступлению в окружающую среду.
Самое очевидное решение — наладить систему сбора и утилизации пластиковых отходов. Это реально сделать: отходы не должны лежать на полигонах, разрушаясь под действием температуры, ветра, солнечного излучения. Их необходимо утилизировать».
